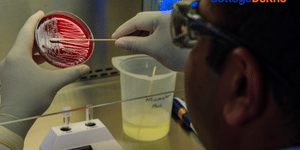
image

About GGC Nizamabad B.Com
GGC Nizamabad B.Com is a 3 Years year program. To be eligible for the B.Com degree program at Girraj Government College, Nizamabad, candidates must have completed their 10+2 education from a recognized board with a minimum aggregate of 50%. Additionally, candidates must have studied Commerce as a subject in their 10+2 education. Admission to the program is based on merit, and candidates may be required to appear for an entrance exam or interview as part of the selection process. It is also important for candidates to meet any additional eligibility criteria set by the college or university. More details about eligibility criteria, fees, admission process, selection criteria, application fees, how to apply, and important dates for GGC Nizamabad B.Com admission are given below:
GGC Nizamabad B.Com is a 3 Years programme offered in specialization like Commerce. The course duration of B.Com at GGC Nizamabad is 3 Years. The B.Com degree helps students to gain profound knowledge and skills that will help them to tackle the real world challenges.
Interested in applying for this course? Visit the official website and submit the application. GGC Nizamabad B.Com admission is offered on the basis of the merit of the qualifying exam.
Once the admission criteria are met, one needs to confirm their admission by paying the GGC Nizamabad B.Com course fees and getting the documents verified.
GGC Nizamabad B.Com Highlights
The table below lists the key details of Girraj Government College B.Com, including its duration, admission process, program type, and available specializations.
| Particulars | Admission Details |
| Duration | 3 Years |
| Program Mode | Regular |
| Specializations | Commerce |
| Application Form | Online |
| Official Website | http://www.ggcnzb.info |
1 Course is offered by GGC Nizamabad
B.Com. (Gen.) U/M
GGC Nizamabad B.Com Eligibility Criteria
Prior to applying for the course it is a mandate for the aspirants to meet the GGC Nizamabad B.Com eligibility criteria. After ensuring that the eligibility criteria is met, submit the application form. One can check the GGC Nizamabad B.Com admission criteria which has been tabulated below.
GGC Nizamabad Eligibility Criteria for B.Com
| Degree | Eligibility Criteria |
| B.Com | To be eligible for the B.Com degree program at Girraj Government College, Nizamabad, candidates must have completed their 10+2 education from a recognized board with a minimum aggregate of 50%. Additionally, candidates must have studied Commerce as a subject in their 10+2 education. Admission to the program is based on merit, and candidates may be required to appear for an entrance exam or interview as part of the selection process. It is also important for candidates to meet any additional eligibility criteria set by the college or university. |
GGC Nizamabad B.Com Admission 2025
Admission to the B.Com at GGC Nizamabad is subject to meeting the eligibility criteria. All shortlisted candidates have to complete the GGC Nizamabad B.Com admission process by getting their documents verified and paying the admission fee.
GGC Nizamabad B.Com Application Process
GGC Nizamabad B.Com application form has to be submitted online by visiting the official website. Candidates aspiring to take admission to the B.Com course at GGC Nizamabad have to first check and meet the eligibility criteria and then proceed further with the application process.
Steps to fill GGC Nizamabad B.Com application form:
- Step 1: Visit the official website of GGC Nizamabad and click on ‘apply online’.
- Step 2: Now, you will be redirected to the admission page of GGC Nizamabad. Complete the registration process and create a profile.
- Step 3: Fill in all details available in the GGC Nizamabad B.Com application form.
- Step 4: Now pay the GGC Nizamabad B.Com application fee and click on submit button.
- Step 5: After the submission, keep a hard copy of GGC Nizamabad B.Com Application Form.
Documents Required for GGC Nizamabad B.Com Admission:
- Marks sheet of class 10th standard
- Marks sheet of class 12th standard
- Transfer certificate (if required)
- Character certificate
- Passport-size photographs
Top Courses at Girraj Government College
GGC Nizamabad Reviews
Placement: "The placement cell of our college is quite active and supportive. Many reputed companies like TCS, Infosys, Wipro, and Deloitte visit the campus every year. The college conducts regular training sessions for aptitude, communication skills, and technical interviews to help students prepare. Around 70-80% of eligible students get placed, especially in IT and management fields. The highest package offered was ₹12 LPA, and the average package ranges between ₹3 to ₹5 LPA. Internships are also provided through college tie-ups with industries. Placement opportunities are better for students from computer science, IT, and management departments."
Infrastructure: The college infrastructure is well-maintained and modern. Classrooms are spacious, equipped with smart boards and proper ventilation. The library is fully stocked with academic and reference books, along with digital access. Laboratories for science and technology are updated and functional. Wi-Fi is available across the campus, and the hostel facilities are clean and secure. Sports grounds, a gym, and a well-designed auditorium add to the overall environment. The campus is also eco-friendly with good greenery and proper waste management systems."
Faculty: "The faculty at our college is knowledgeable, approachable, and supportive. Most professors have strong academic backgrounds and explain concepts clearly with real-world examples. They are open to doubts and encourage interactive learning in class. Some faculty members also provide extra sessions before exams and guide us in projects and internships. While a few teachers are stricter or more traditional in their teaching style, overall, the faculty contributes greatly to our academic growth and success."
Hostel: "Hostel life at my degree college has been one of the most memorable parts of my journey. The hostel provides a decent living environment with clean rooms, 24/7 water and electricity supply, and basic furniture. There’s a shared common area where students hang out, study, or watch TV together. The mess serves decent food with a balanced diet, though it can get repetitive. Wardens are supportive, and there’s enough security to ensure student safety. Most importantly, hostel life taught me independence, time management, and gave me a strong circle of friends from different backgrounds. Late-night group studies, birthday celebrations, and bonding over chai made hostel life truly special."
Similar Colleges
Explore More Engineering Colleges in Telangana
By Degree
By Specialization
- Colleges in Nizamabad
- GGC Nizamabad
- GGC Nizamabad Courses & Fees
- B.Com. (Bachelor of Commerce)